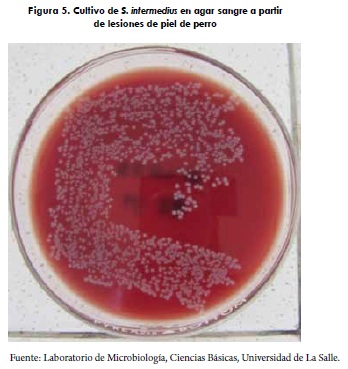

Services on Demand
Journal
Article
Indicators
-
Cited by SciELO -
Access statistics
Related links
-
Cited by Google -
Similars in
SciELO -
Similars in Google
Share
Revista de Medicina Veterinaria
Print version ISSN 0122-9354On-line version ISSN 2389-8526
Rev. Med. Vet. no.22 Bogotá July/Dec. 2011
Aislamiento e identificación bioquímica
de microorganismos bacterianos a partir
de infecciones de piel en caninos
Iovana Castellanos L.1 / Germán Rodríguez M.2 / Rosario Santos A.3
1 Médica veterinaria, MSc (c). Grupo de investigación Cimra, Universidad de La Salle.
iocastellanos@unisalle.edu.co
2 Médico veterinario, zootecnista, MSc, PhD. Grupo de Investigación Cimra, Universidad de La Salle.
grodriguezm@unisalle.edu.co
3 Bióloga, MSc (c) Laboratorio de Microbiología, Departamento de Ciencias Básicas, Universidad de La Salle.
rsantos@lasalle.edu.co
Recibido: 5 de mayo del 2011. Aceptado: 21 de septiembre del 2011
Resumen
Las dermatitis bacterianas o piodermas en caninos son ocasionadas por microorganismos patógenos, de los cuales el Staphylococcus intermedius es el más frecuente. Los tratamientos empíricos de este grupo de enfermedades permiten la proliferación de cepas resistentes de importancia en salud pública como es el caso del S. aureus. De igual forma, el riesgo de zoonosis reversa a partir de mascotas portadoras de cepas resistentes crea un serio problema de salud pública que requiere vigilancia epidemiológica. El objetivo de la investigación fue aislar e identificar bioquímicamente los microorganismos presentes en infecciones de piel en caninos; para esto se obtuvieron las muestras de caninos con problemas dermatológicos, y se identificaron los microorganismos bacterianos involucrados utilizando el kit de identificación rápida BBL Crystal para grampositivos. Los resultados obtenidos demostraron que el 80% de los aislamientos correspondieron a S. intermedius. Sin embargo, es necesario realizar estudios moleculares para relacionar la severidad de las lesiones dermatológicas con la identificación de los estafilococos presentes en el pioderma, y así establecer medidas de control, tratamiento y profilaxis.
Palabras clave: pioderma, Staphylococcus sp, BBL Crystal, grampositivos.
Isolation and Biochemical Identification of Bacterial
Organisms from Skin Infections in Dogs
Abstract
Bacterial dermatitis or pyoderma in dogs are caused by pathogenic microorganisms, among which Staphylococcus intermedius is the most common. The empirical treatment of this group of diseases allows the proliferation of resistant strains that are significant for public health in the case of S. aureus. Similarly, the risk of reverse zoonoses from pet carriers of resistant strains creates a serious public health issue that requires epidemiological surveillance. The objective of the research was the biochemical isolation and identification of the microorganisms present in skin infections in dogs; samples were taken from dogs with skin problems for this purpose, and the bacterial organisms involved were identified by using the BBL Crystal Rapid Gram-Positive ID Kit. Results showed that 80% of the isolates corresponded to S. intermedius. However, molecular studies are required to relate the severity of skin lesions with the identification of staphylococci present in pyoderma, and thus be able to establish control, treatment and prophylaxis measures.
Keywords: Pyoderma, Staphylococcus sp, BBL Crystal Gram-positive.
Isolamento e identificação bioquímica de micro-organismos
bacterianos a partir de infecções da pele em caninos
Resumo
As dermatites bacterianas ou piodermites em caninos são ocasionadas por micro-organismos patógenos, dos quais o Staphylococcus intermedius é o mais frequente. Os tratamentos empíricos deste grupo de doenças permitem a proliferação de cepas resistentes de importância em saúde pública como é o caso do S. aureus. De igual forma, o risco de zoonose reversa a partir de mascotes portadores de cepas resistentes cria um sério problema de saúde pública que requer vigilância epidemiológica. O objetivo da pesquisa foi isolar e identificar bioquimicamente os micro-organismos presentes em infecções de pele em caninos; para isto se obtiveram as mostras de caninos com problemas dermatológicos, e se identificaram os micro-organismos bacterianos envolvidos utilizando o kit de identificação rápida BBL Crystal para Gram positivos. Os resultados obtidos demonstraram que 80% dos isolamentos corresponderam a S. intermedius. Entretanto, é necessário realizar estudos moleculares para relacionar a severidade das lesões dermatológicas com a identificação dos estafilococos presentes na piodermite, e assim estabelecer medidas de controle, tratamento e profilaxia.
Palavras chave: piodermite, Staphylococcus sp, BBL Crystal, Gram positivos.
Introducción
Las enfermedades bacterianas cutáneas (pioder-mas) son frecuentes en caninos, sin embargo, existe una flora microbiana normal en la superficie de la epidermis y en los infundíbulos de los folículos pilosos que contribuye a su bienestar y que puede cambiar por factores ambientales como la humedad, el pH y la salinidad (Matousek y Campbell, 2002; Scott et ál., 2001).
Durante muchos años, cuatro especies de estafilococos han sido reconocidas y documentadas como patógenas: S. aureus, S. intermedius, S. hyicus y S. schleiferi subespecie coagulans (Morris et ál., 2006). Las especies de estafilococos coagulasa positivos (>90%) son consideradas como patógenas primarias y más virulentas que las especies coagulasa negativas (<10%) (Kania et ál., 2004). Los estafilococos coagulasa negativos han sido asociados con infecciones en personas y en caninos, y por ello son de importancia zoonótica. El S. aureus es el patógeno predominante en humanos, mientras el S. intermedius y el S. schleiferi son los patógenos primarios en los caninos. Las especies coagulasa variable afectan humanos y parecen ser patógenas emergentes en medicina veterinaria (Kania et ál., 2004). Las variantes del S. schleiferi, subespecies schleiferi y subespecies coagulans, han sido reconocidas como patógenas en caninos y humanos (Morris et ál., 2006); la importancia de esta bacteria ha crecido en los últimos años debido a su aislamiento en perros con pioderma, y en humanos donde ha sido documentada como patógena en pacientes con heridas infectadas, endocarditis, osteomielitis, bacteremia, infecciones del tracto urinario y, más recientemente, en meningitis (Frank et ál., 2003).
De igual forma, se ha reportado la asociación de Staphylococcus intermedius con Streptococcus agalactie pertenecientes al grupo B, los cuales son aislados principalmente de humanos y bovinos pero ocasionalmente producen infecciones en perros, gatos, camellos, ranas y peces; causan septicemia en perros, y endocarditis, infecciones de piel y tejidos blandos, y osteomielitis en humanos (Fortin y Higgins, 2001). También han sido aislados Proteus sp, Pseudomonas y E. coli acompañados de S. intermedius, y se reporta el aislamiento único de Pseudomonas aeruginosa de pioderma y de casos en otitis crónica externa en caninos, donde es un patógeno frecuente y primario (Hillier et ál., 2006; Schick et ál., 2007). Eventualmente, algunas mico-bacterias también se han observado en infecciones dermatológicas en caninos.
El Staphylococcus intermedius fue descrito por primera vez en 1976 por Hajek, y ha sido considerado como una bacteria residente de la piel de los caninos y de las mucosas de la cavidad oral, nasal, perineo y ano; en condiciones normales inhiben la colonización de organismos patógenos, pueden ser reducidas, pero no eliminadas, con el uso de antibióticos, y establecen simbiosis con poblaciones bacterianas mixtas (Nesbitt y Ackerman, 2001), sin embargo, también han sido consideradas los principales patógenos primarios de las infecciones bacterianas de la piel y el oído en caninos (Fitzgerald, 2009; Loeffler et ál., 2007; Scott et ál., 2001; Pinchbeck et ál., 2006), y son el origen de la población encontrada en la superficie de la piel y el pelo posiblemente por transporte desde estos sitios donde pueden causar la contaminación de la piel durante la peluquería o debido a los comportamientos pruríticos (Pinchbeck et ál., 2006). Una vez se rompen los mecanismos de defensa de la piel, estas bacterias patógenas invaden en forma primaria o secundaria causando enfermedad (pioderma). La habilidad de estas bacterias para colonizar la piel depende de varios factores como son la utilización de los nutrientes disponibles en la piel, la resistencia al desafío de las bacterias competidoras, la habilidad para soportar las fuerzas abrasivas del huésped y la adherencia a los corneocitos (Forsythe et ál., 2002).
El uso de agentes antimicrobianos incrementa dramáticamente la presión sobre las bacterias que deben explorar caminos efectivos para evitar ser inhibidas o morir por el uso de dichos agentes (Schwarz y Noble, 1999). El tratamiento de las infecciones bacterianas de la piel rutinariamente se ha basado en la selección empírica de antimicrobianos con conocida eficacia contra Staphylococcus spp. (Morris et ál., 2006; Ganière et ál., 2001); no obstante, la respuesta a la antibioticoterapia varía dependiendo de la especie bacteriana y, de igual forma, la vigilancia epidemiológica frente al reporte de cepas de S. aureus meticilino-resistentes (MRSA) a partir de animales requiere un tratamiento adecuado y la implementación de medidas de control en la población humana y animal tendientes a su erradicación.
En Colombia no existen reportes de estudios de aislamientos de microorganismos a partir de lesiones cutáneas sugestivas de piodermas en caninos; por este motivo, en el presente artículo se presentan los resultados del aislamiento microbiológico y la identificación bioquímica de los microorganismos involucrados, utilizando kits rápidos de identificación de agentes bacterianos a partir de muestras nativas en una población de caninos en la ciudad de Bogotá.
Materiales y métodos
Las muestras se obtuvieron de cuarenta caninos de diferentes clínicas y consultorios veterinarios en la ciudad de Bogotá; los pacientes presentaron dermatitis con lesiones sugestivas de pioderma superficiales y profundas, sin tratamiento de antibiótico las dos semanas anteriores a la toma de las muestras. Las muestras se obtuvieron mediante hisopados de piel, teniendo en cuenta el aspecto macroscópico de las lesiones como costras, pápulas, pústulas, escoriación, alopecia, collaretes epidérmicos y eritema. Se diligenciaron tablas de registro incluyendo la raza, la edad, el sexo, el tipo y la localización de las lesiones de cada paciente.
Aislamiento de Staphylococcus sp
Se tomaron las muestras con hisopos estériles y se transportaron refrigeradas en medio Stuart al laboratorio de Microbiología de Ciencias Básicas de la Universidad de La Salle. Posteriormente, se cultivaron en agar sangre ® (Oxoid) y se llevaron a incubar a 37 °C durante 24 horas. Se analizó la morfología macroscópica y microscópica (coloración de Gram) de las colonias hasta su completo aislamiento. Adicionalmente, las colonias aisladas se cultivaron en medio selectivo y diferencial para el aislamiento y diferenciación de estafilococos como el Salado Manitol ® (Oxoid), y se realizó la prueba de la coagulasa inoculando las colonias aisladas con plasma humano e incubándolas a 37 °C durante 12 horas.
Identificación bioquímica con BBL Crystal
La identificación bioquímica de Staphylococcus sp. se realizó mediante la utilización del kit de diagnóstico rápido BBL Crystal® para bacterias grampositivas. Esta prueba contiene 29 sustratos enzimáticos, bioquímicos, fluorogénicos y cromogénicos. Para esto se tomaron colonias de 24 horas de crecimiento a 37 oC, y se inocularon en los tubos contenidos en el BBL Crystal con una concentración equivalente al tubo 5 de la escala de McFarland (NTC 245 5); posteriormente, los paneles se llevaron a incubar a 37 oC durante 24 horas. Se realizó la lectura con cámara UV a 360 nm con el software respectivo.
Resultados
Dentro del estudio se incluyó una población heterogénea conformada por 13 caninos machos (32%) y 27 hembras (68%). Dentro de las razas estudiadas, el mayor porcentaje fue la raza criolla (32%), seguido de las razas labrador (12%), poodle (8%), schnauzer (8%), pitbull (8%), bóxer (5%), pastor siberiano (5%). El 22% correspondió a caso único de las razas samoyedo, cocker, pointer, golden retriever, bulldog, pug, pastor malinois, dashound y beagle.
En el estudio se incluyeron pacientes caninos con edades comprendidas entre 3 meses y 13 años. Se establecieron tres grupos de edad: cachorros (0 a 12 meses), adultos (2-7 años) y gerontes (mayores de 7 años). El mayor porcentaje de la población se ubicó en el grupo de los adultos (42%), seguidos de los casos en pacientes cachorros hasta 1 año (38%) y gerontes (20%). La figura 1 muestra la edad de la población estudiada en perros con enfermedades cutáneas.
Durante este estudio se tuvieron en cuenta los pacientes con enfermedad dermatológica que no recibieron medicamentos en las dos semanas previas a la toma de las muestras. En todos los casos se observaron dos o más tipos de lesiones primarias como pápulas y pústulas con lesiones secundarias como alopecia, costras, escoriaciones o collaretes epidérmicos; las lesiones más frecuentemente encontradas fueron pápulas, seguidas de alopecias y costras (figura 2).
Se encontraron lesiones principalmente en miembros (26%) y abdomen (26%); al mismo tiempo, se observó que las lesiones en los miembros se ubicaron predominantemente en los espacios interdigitales y en la región de las bragadas. De igual forma, se encontraron lesiones en la cabeza y el cuello (21%), principalmente en la superficie dorsal del pabellón auricular, el mentón y la región periocular, seguida de las lesiones en el dorso (14%); las lesiones generalizadas fueron las de menor presentación (6%), como puede observarse en la figura 3.
Se obtuvo crecimiento bacteriano en los 40 casos estudiados. De estos, en 4/40 (10%) de ellos se obtuvo el crecimiento de más de una colonia; en los 36/40 (90%) restantes se obtuvo el crecimiento de un solo tipo de colonia bacteriana. En total se aislaron 54 colonias. El 80% de los aislamientos correspondió a S. intermedius (43 aislamientos), seguidos del 4% de S. schleiferi (2 aislamientos). Los resultados de los agentes etiológicos aislados se presentan en la figura 4. En la figura 5 se observa la morfología de las colonias bacterianas de S. intermedius.
Con el uso del kit BBL Crystal para grampositivos el 97% (41 aislamientos) de los S. intermedius se identificaron con el 100% de certeza, solo dos de ellos fueron identificados con el 99 y el 64% de confianza. De S. schleiferi var. coagulans se obtuvieron dos casos que fueron identificados con el 99 y el 81% de certeza. En el caso de los estreptococos, el Streptococcus pyogenes fue identificado con el 98%, el Streptococcus salivarius con el 92%, y el Streptococcus haemolyticus con el 81%; para el resto de microorganismos, el Bacteroides megaterium fue aislado con un 62% y Lactococo galvani con 63% de certeza.
Se registró el crecimiento en el agar salado manitol; sin embargo, no hubo cambio de color en el medio, descartando la presencia de S. aureus. De la misma manera, la prueba de la coagulasa dio positiva para microorganismos como S. intermedius y S. schleiferi var. coagulans (figura 6), mientras que para S. epidermidis y S. xylosus la prueba fue negativa.
Discusión
Las dermatitis bacterianas primarias y secundarias a un proceso primario de la piel son muy comunes en pequeños animales, y son la manifestación clínica más frecuente de la presencia de estafilococos; esto ha llevado al uso empírico de antimicrobianos con actividad reconocida contra bacterias de este tipo, sin tener en cuenta la especie y la creación de cepas resistentes a estos agentes antimicrobianos (Morris et ál., 2006; Scott et ál., 2001).
En el presente estudio, el 80% de los aislamientos correspondió a S. intermedius, tradicionalmente reconocido como el microorganismo más común que participa como agente patógeno primario u oportunista en estas afecciones (Morris et ál., 2006; Scott et ál., 2001); sin embargo, se identificaron cepas de S. schleiferi var. coagulans, un patógeno emergente en medicina veterinaria, de importancia en medicina humana (Kania et ál., 2004), y de igual forma, se aislaron e identificaron cepas de estafilococos consideradas parte de la flora residente normal de la piel del perro como son el S. xiloxus y el Micrococcus luteus. (Scott et ál., 2001) . Se ha reportado la presencia de cepas de S. aureus aislados de la piel de los caninos como un problema de salud pública por los riesgos de zoonosis reversa, donde los caninos pueden actuar como reservorios de cepas resistentes obtenidas de sus propietarios, y ser potenciales agentes zoonóticos en caso de enfermedad inmunosupresora o debilitante de los mismos, lo que constituye un grave problema de salud pública para el cual los médicos veterinarios deben estar preparados a fin de afrontar y establecer las medidas de control necesarias (Hoekstra y Paulton, 2002) ; aunque en el estudio no se identificaron estos microorganismos, es importante la vigilancia epidemiológica permanente en la identificación de estas cepas, para que una vez sean tipificadas, se compruebe su sensibilidad antimicrobiana y, en casos de resistencia, se tomen las medidas de control apropiadas. De igual forma, este resultado confirma la variedad de los microorganismos en las diferentes regiones del mundo, aunque las tendencias sean similares, y se debe tener en cuenta que aunque el S. intermedius sigue siendo el microorganismo más frecuentemente aislado en casos de piodermas en caninos, no es exclusivo y pueden estar involucrados diferentes microorganismos y especies del mismo que se deben considerar en un momento dado.
En general, los aislamientos fueron de especies bacterianas únicas en el 90% de los casos; no obstante, se observó la presencia de estafilococos coagulasa negativos y estreptococos patógenos en los casos de lesiones ulceradas de la piel, lo que permite sugerir una mayor contaminación por microorganismos bacterianos en este tipo de lesiones, y la necesidad de realizar cultivos para la identificación de los microorganismos involucrados a fin de poder decidir con certeza los agentes antimicrobianos que se deben utilizar para el tratamiento de estas lesiones.
Los aspectos relacionados con la edad, la raza y el sexo de los pacientes son importantes, sin embargo, no son representativos en este estudio por el desconocimiento de los aspectos poblacionales de los caninos en nuestro medio. No obstante, la ubicación de las lesiones con un mayor porcentaje a nivel de los miembros y el abdomen puede asociarse con la facilidad de acceso a estos sitios con conductas como el rascado y el lamido, frecuentemente observadas en estos pacientes, y que podrían explicar el aislamiento de cepas que bien pueden ser trasladadas de los sitios de ubicación normal de los estafilococos a los sitios de trauma.
El crecimiento bacteriano en todos los casos de dermatopatías estudiadas indica la presencia del S. intermedius como habitante normal y patógeno oportunista en la enfermedad dermatológica; a su vez, es necesario seguir investigando sobre participación del S. intermedius y del S. pseudointermedius en la severidad de la lesión dermatológica a partir de estudios moleculares para así lograr diferenciarlos y tener un diagnóstico confiable ya que las pruebas de bioquímica convencional no lo permiten.
Agradecimientos
Especial agradecimiento a la doctora Patricia Jiménez de Borray y al doctor Ricardo Montealegre, pertenecientes al Departamento de Ciencias Básicas de la Universidad de La Salle, por el apoyo para el desarrollo del trabajo, de igual manera a los médicos veterinarios Consuelo Castillo, Sergio Arias, Mauricio Merizalde, César Fajardo, Jorge Alberto Castañeda y Ricardo Sierra por su colaboración con la casuística.
Referencias
Fitzgerald, J. R. (2009). The Staphylococcus intermedius group of bacterial pathogens: species re-classification, pathogenesis and the emergence of meticillin resistance. Veterinary Dermatology, 20, 490-495. [ Links ]
Forsythe, P. J., Hill, P. B., Thoday, K., Jeremy, L., Brown, J. (2002). Use of computerized image analysis to quantify staphylococcal adhesion to canine corneocytes: does breed and body site have any relevance to the pathogenesis of pyoderma? Veterinary Dermatology, 13, 29-37. [ Links ]
Fortin, M. and Higgis, R. (2001). Mixed infection associated with a group B Streptococcus in a dog. Can Vet J., 42, 730. [ Links ]
Frank, L., Kania, S. A., Hnilica, K. A. et ál. (2003). Isolation of Staphylococcus schleiferi from dogs with pioderma. JAVMA, 222 (4), 451-454. [ Links ]
Ganière, J. P., Médaille, C., Limet, A., Ruvoen, N. and André-Fontaine, G. (2001). Antimicrobial activity of enrofloxacin against Staphylococcus intermedius strains isolated from canine pyodermas. Veterinary Dermatology, 12, 171-175. [ Links ]
Hajek, V. (1976). Staphylococcus Intermedius, a new species isolated from Animals. Internacional Journal of Systematic bacteriology, 26, 401-408. [ Links ]
Hillier, A., Alcorn, J. R., Cole, L. K. and Kowalski, J. (2006). Pyoderma caused by Pseudomonas aeruginosa infection in dogs: 20 cases. Veterinary Dermatology, 17, 432-439. [ Links ]
Hoekstra, K. A., Paulton, R. J. L. (2002). Clinical prevalence and microbial susceptibility of Staph. Intermedius in dogs Journal of Applied Microbyology, 93, 406-413. [ Links ]
Kania, S. A., Williamson, N. L., Frank, L. A. et ál. (2004). Methicillin resistance of staphylococci isolated from the skin of dogs with pioderma. American Journal Veterinary Research, 65 (9), 1265-1267. [ Links ]
Loeffler, A., Linekt, M. and Moodley, A. (2007). First report of multiresistant, mecA-positive Staphylococcus intermedius in Europe: 12 cases from a veterinary dermatology referral clinical compilation. ESVD, 18, 412-421. [ Links ]
Matousek, J. L. and Campbell, K. L. (2002). A comparative review of cutaneous pH. Veterinary Dermatology, 13, 293-300. [ Links ]
Morris, D. O., Rook, K. A., Shofer, F. S. y Rankn, S. C. (2006). Screening of Staphylococcus aureus, Staphylococcus intermedius, and Staphylococcus schleiferi isolates obtained from small companion animals for antimicrobial resistance: a retrospective review of 749 isolates (2003-04). Veterinary Dermatology, 17, 332-337. [ Links ]
Nesbitt, G. H. y Ackerman, L. J. (2001). Dermatología canina y felina. Diagnóstico y tratamiento. Intermédica, 188-210. [ Links ]
Pinchebeck, L. R., Cole, L. K., Hillier, A. et ál. (2006). Genotipic relatedness of staphylococcal strains isolated from pustules and carriage sities in dogs with superficial bacterial foliculitis. American Journal Veterinary Research, 67, 1337-1345. [ Links ]
Schick, A., Angust, J. K. and Corney, K. (2007). Variability of laboratory identification and antibiotic susceptibility reporting of Pseudomonas spp. Isolates from dogs with cronic otitits externa. Journal compilation, 18, 120-126. [ Links ]
Schwarz, S., Noble, W. C. (1999). Aspects of bacterial resistance to antimicrobials used in veterinary dermatology practice. Veterinary Dermatology, 10, 163-176. [ Links ]
Scott, D. W., Miller, W. H. y Griffin, C. E. (2001). Small Animal Dermatology. 6ta edition. WB Saunders, 4, 274-335. [ Links ]